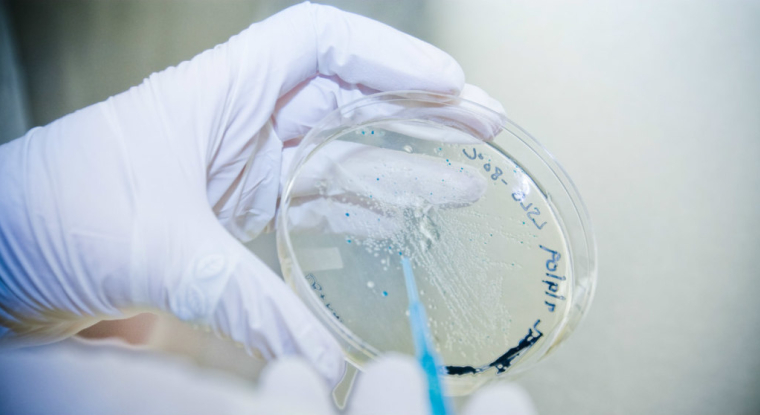
Un nouvel échec fait lourdement chuter le titre AB Science. (© cc HCC)

Un nouvel échec fait lourdement chuter le titre AB Science. (© cc HCC)
L’histoire de répète pour AB Science … Près d’un an après que l’Agence européenne du médicament (AME) a refusé la mise sur le marché de son candidat-médicament phare, le masitinib, pour traiter la masotcytose, la biotech vient d’essuyer un nouveau camouflet sur ce produit.
Le Comité du médicament à usage humain (CHMP) a émis, cette fois-ci, une option négative sur la demande de commercialisation du masitinib pour traiter la sclérose latérale amyotrophique chez l’adulte, une maladie dégénérative rare. Elle touche environ 50.000 personnes dans l’Union européenne et aux États-Unis.
L’institution n’y est pas allée de main morte pour justifier sa décision. Elle reproche à AB Science de ne pas avoir fourni des données assez robustes pour justifier une approbation de mise sur le marché pour son candidat-médicament.
Elle indique aussi ne pas trouver de «pertinence clinique» de la distinction faite entre les patients de l’étude dont la progression de la maladie est «normale» et ceux chez qui elle est «rapide».
Sanction boursièreEnfin, le design de l’étude pourrait induire, selon le CHMP, des biais dans les résultats, à cause de l’inclusion de données de patients ayant quitté le programme prématurément.
La sanction boursière a été immédiate : le cours d’AB Science reculait de 26% ce 20 avril en fin de matinée. Depuis que




0 commentaire
Vous devez être membre pour ajouter un commentaire.
Vous êtes déjà membre ? Connectez-vous
Pas encore membre ? Devenez membre gratuitement
Signaler le commentaire
Fermer